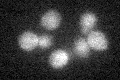
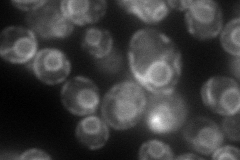
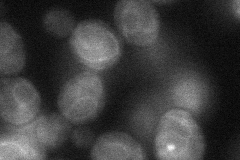

View description
Glucosyl transferase, involved in N-linked glycosylation; adds glucose to the dolichol-linked oligosaccharide precursor prior to transfer to protein during lipid-linked oligosaccharide biosynthesis; similar to Alg6p
Localization:
Intensity:
Fold change:
Significance:
-
C’ GFP library in SD
below threshold18.81 -
N' NOP1pr-GFP in SD

ER107.683 -
N' TEF2pr-mCherry in SD
ER113.923 -
N' NATIVEpr-GFP in SD

ER34.3525 -
N' TEF2pr-VC and Cyto-VN in SD
ER41.2022 -
C’ GFP library in SD+DTT

cytosol15.180.8No -
C’ GFP library in SD+H2O2

cytosol17.390.92No -
C’ GFP library in Starvation Media

cytosol16.860.89No -
C’ GFP library on the background of Pup2-DaMP

below threshold -
C’ GFP library on the background of CCT mutant

below threshold16.38450.870819No
